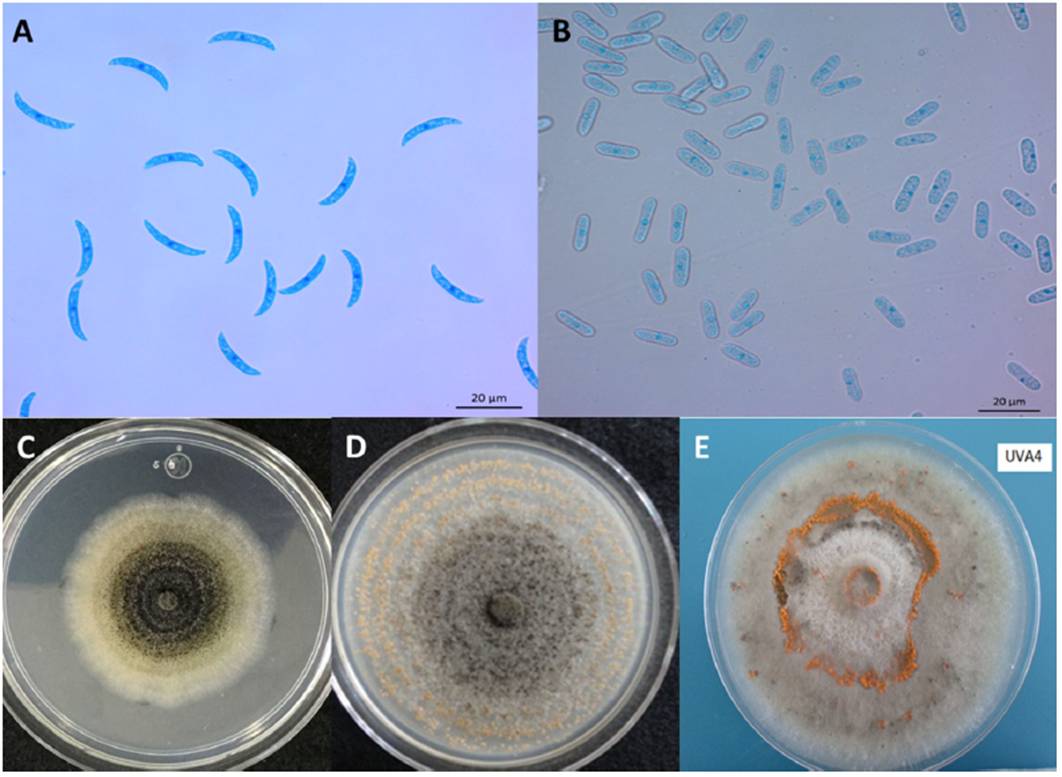

Servicios Personalizados
Revista
Articulo
Indicadores
-
 Citado por SciELO
Citado por SciELO -
 Accesos
Accesos
Links relacionados
-
 Similares en
SciELO
Similares en
SciELO
Compartir
Revista mexicana de fitopatología
versión On-line ISSN 2007-8080versión impresa ISSN 0185-3309
Rev. mex. fitopatol vol.35 no.3 Texcoco sep. 2017
https://doi.org/10.18781/r.mex.fit.1703-9
Review articles
Current status of Colletotrichum spp. in Mexico: Taxonomy, characterization, pathogenesis and control
1Centro de Investigación en Alimentación y Desarrollo, A. C. Coordinación Culiacán. Carretera Culiacán-El dorado km 5.5, Campo El Diez, CP. 80110, Culiacán, Sinaloa, México.
Colletotrichum species are causal agents of anthracnose in a wide host range. According to taxonomic studies, Colletotrichum is phylogenetically classified into nine clades; the molecular identification of especies complexes is based on different conserved genomic regions. In Mexico, 46 Colletotrichum species have been reported, from which 28 were identified at morphological level and 18 at molecular level. The main species reported are C. gloeosporioides and C. truncatum as they affect a great number of hosts such as papaya, chili, mango, lemon, avocado, among others. This wide range of hosts may be because these species have different infection strategies according to the host: intramural subcuticular colonization or intracelular colonization. Control strategies for Colletotrichum spp. include physical, chemical and biological control, among others. The objective of this review is to know the status of Colletotrichum species in Mexico.
Key words: Anthracnose; C. gloeosporioides; C. truncatum; infection strategies
Las especies del género Colletotrichum son agentes causales de antracnosis en un amplio rango de hospedantes. De acuerdo con estudios taxonómicos, Colletotrichum se clasifica filogenéticamente en 9 clados; la identificación molecular de los complejos de especies se basa en distintas regiones genómicas conservadas. En México, se han reportado 46 especies de las cuales 28 se identificaron a nivel morfológico y 18 a nivel molecular. C. gloeosporioides y C. truncatum son las principales especies reportadas que afectan a un mayor número de hospedantes como papaya, chile, mango, limón y aguacate, entre otros. Este rango amplio de hospedantes puede deberse a la habilidad del hongo de emplear diferentes estrategias de infección: colonización intramural subcuticular o colonización intracelular. Las estrategias de control en Colletotrichum spp. incluyen control físico, químico y biológico, entre otras. El objetivo de esta revisión consiste endescribir el estado actual de las especies de Colletotrichum en México.
Palabras clave: Antracnosis; C. gloeosporioides; C. truncatum; estrategias de infección
Colletotrichum is a genus of phytopathogen fungi that causes diseases such as cancer, rot, and particularly anthracnose to different hosts. Colletotrichum symptoms appear as semicircular lesions with sunken areas like concentric rings (Figure 1) (Hyde et al., 2009a). Anthracnose has been reported world wide in fruit, vegetales, cereals, herbaceous plants, timber crops and ornamental plants, among other (Udayanga et al., 2013).

Figure 1 Anthracnose symptoms caused by Colletotrichum spp. A) Colletotrichum sp. in leaves of Mexican lemon; B) C. circinans in onion (Taken from Montes-Belmont et al., 2003); C) C. gloeosporioides in lychee (Taken from Martínez-Bolaños et al., 2015); D) and E) C. truncatum and C. gloeosporioides in papaya; F) C. gloeosporioides in mango.
Colletotrichum includes over 100 species responsible for anthracnose in almost all food, fiber and forage crops worldwide, including C. gloeosporioides, C. truncatum, C. lineola, C. boninense (Crouch et al., 2014). Due to its scientific and economic importance, Colletotrichum species were ranked eighth in the world classification of plant pathogens (Dean et al., 2012).
Anthracnose causes major pre- and postharvest losses by reducing the quality and quantity of various crops. Losses may reach up to 100 % depending on the pathogen and weather conditions (Landero-Valenzuela et al., 2016). For example, in intensive papaya crops under fungicide management, the prevalence of anthracnose in the field and postharvest has caused losses greater than 50 % (Torres-Calzada et al., 2013).
The population diversity of Colletotrichum from previous reports is complicated because of the lack of tools to identify the species and because the traditional methods were based on morphological differences that nowadays are known to be in adequate and innacurate (Hyde et al., 2009b).
Although there is diverse information about Colletotrichum spp., in Mexico there are no publications describing the Colletotrichum species that have been studied locally nor of the hosts reported to have caused damage. Therefore, the objective of this study was to describe the current status of Colletotrichum in Mexico through a review of published results from taxonomy, identification, reported species, pathogenesis and control.
TAXONOMY
Colletotrichum includes the asexual stage (anamorph) of the Glomerella (teleomorph) species that belongs to Phyllum Ascomycota, Hypocreomycetidae class, Glomerellales order, Glomerellaceae family (Réblová et al. 2011). Glomerellaceae is a monotypical family characterized by non-stromatic dark perithecia, well-developed paraphysed ostioles and abundant thin-walled paraphyses. Glomerella was initially considered a member of the order Phyllacorales, but some of its characteristics are clearly different from those of other members; for example, the lack of stromatic tissue and anamorphs specific to Colletotrichum (Zhang et al., 2006).
Colletotrichum is a taxonomically confusing genus because the name of the genus varies depending on its sexual state. In 2012, members of the International Subcommittee on Taxonomy of Colletotrichum (ISTC) supported the use of the term Colletotrichum over Glomerella because it is more widely used in applied science, and this created the expectation to make minor taxonomic changes in the species of that genus (Damm et al., 2010; Zhang et al., 2013).
Identifying important Colletotrichum species still requires further studies, and although the molecular and phylogenetic techniques improve the accuracy of the traditional morphological and biochemical methods, what is needed is an integrated diagnosis that is more solid.
Based on phylogenetic analysis, species complexes have been identified within the Colletotrichum genus which are classified into nine major clades: acutatum clade (includes 29 species) (Damm et al., 2012a), boninense clade (27 species) (Damm et al., 2012b), destructivum clade (13 species) (Damm et al., 2014), gloeosporioides clade (22 species) (Weir et al., 2012), orbiculare clade (8 species) (Damm et al., 2013), graminicola clade (13 species), dematium clade (6 species), spaethianum clade (5 species) and truncatum clade (3 species) (Cannon et al., 2012; Udayanga et al., 2013).
IDENTIFICATION
Morphological
Traditionally, the Colletotrichum genus has been identified through morphological traits such as: conidia size and shape, and appressoria; presence or absence of setae, sclerotia, acervuli, teleomorph stage, as well as cultural characteristics, such a colony color, texture and growth rate (Hyde et al., 2009b). C. truncatum exhibits unicellular conidia 22.8-23.8 x 3-3.02 µm in size, smooth-wall hyalines without septa; generally the central part is slightly curved, has parallel walls, and ends abruptly in a round short base with granular content. (Figure 2A). In contrast, C. gloeosporioides presents ovoid conidia 13.56-14.24 x 4 - 4.02 µm in size (Figure 2B). C. truncatum colonies are circular or irregular, with entire margin, white-to-salmon or gray-to-black coloration and conidial masses produced in concentric rings (Figure 2C); C. gloeosporioides colonies exhibit radial mycelial growth, with entire or ondulated margin usually white in color with orange conidial masses in the middle of the colony (Figure 2D). On the other hand, Colletotrichum presents different morphotypes, for example, circular and with entire margin, mycelium gray in color with orange conidial masses (Figure 2E) (Torres-Calzada et al., 2012).
Figure 2 Morphological characteristics of the main Colletotrichum species in Mexico. A) C. truncatum asexual conidia; B) C. gloeosporioides asexual conidia; C) Colony morphology of C. truncatum in PDA; D) Colony morphology of C. gloeosporioides in PDA; E) Colony morphology of Colletotrichum sp. isolated from orange.
According to Barnett and Hunter (1998), Colletotrichum is a genus characterized by exhibiting waxy, subepidermal and separate acervuli shaped like disks or cushions that emerge from the host plant; typically they contain setae or black spines at the edges or among conidiophores; conidiophores are simple and elongated while conidia are hyaline and ovoid or oblong. Not all the Colletotrichum species have ovoid or oblong conidia, since there are species that produce curved conidia, such as C. dematium and C. lineola (Damm et al., 2009).
Crouch et al. (2009a) consider that conidia shape and size, just as in appressoria, are of little taxonomic use to characterize cereal grain species. Species with similar morphological characteristics may be highly variable at physiological and pathogenic levels due to environment or incubation conditions, among other factors. Furthermore, their morphological characteristics are not enough for diagnosis because of the great variation on the phenotype morphology among species under different environment conditions (Cai et al., 2009). To address such deficiencies in traditional identification, the combined use of molecular characterization along with the traditional diagnosis are currently considered an appropriate technique to study complexes in Colletotrichum species (Hyde et al., 2009b).
Molecular
Due to the limitations of the traditional identification approaches, nucleic acid analysis is considered a reliable technique for identifying Colletotrichum species. However, a very important disadvantage of depending on a small portion of the genome to understand the phylogenetic relationships between isolates of Colletotrichum is the risk of creating phylogenetic trees of genes instead of phylogenetic trees of species; therefore, phylogenetics of multiple genes has been used to systematically characterize the relationships among Colletotrichum species, which serves as a base for identification in a complex of species (Cai et al., 2009).
Currently, conserved gene regions or genetic barcodes are used to identify fungal species. The most used region is the internal transcribed spacer (ITS) of nuclear ribosomal DNA (Schoch et al., 2012). As for Colletotrichum spp., to study the Colletotrichum species closely related, in addition to the ITS region, other regions are also used such as: partial actin (ACT), β-tubulin (TUB2), calmodulin (CAL), glutamine synthetase (GS), chitin synthase (CHS1), histamine (HIS3), lyase (APN2), apn2 intergenic region and MATI-2-1 (ApMat), and glyceraldehyde 3-phosphate dehydrogenase (GAPDH) (Cai et al., 2009; Hyde et al., 2014). Phylogenetics of multiple genes genes has been successfully applied to determine relations among species with curved conidia in herbal hosts. An example of this are the new taxon of C. hanaui, C. nicholsonii, C. paspali species, among others (Crouch et al., 2009a).
Although phylogenetics of multiple genes is an accurate and reliable method to diagnose Colletotrichum spp., it is not very efficient or economically viable. It is currently impractical to use phylogenetics of multiple genes for all the species, and this is the reason why different research groups use different gene regions. The ITS region continues to be the most sequenced, but its sequences are not completely realiable for discriminating among Colletotrichum species (Cai et al., 2009), given that, for example, Crouch et al. (2009b) reported a high rate of identification errors (86 %) based on sequences compared within the complex of C. lineola species. On the other hand, the ITS sequences deposited in public databases (Genbank) can cause confusion because sequences are introduced into them under the wrong names or they may include cryptic species.
Therefore, the study of the genotype includes sequencing to combine phylogenetic traits, while the phenotypic study should be expanded to a polyphasic sense to include morphology, physiology, pathogenicity, infection process, cultural characteristics and secondary metabolites (Cai et al., 2009). Thus, both studies about Colletotrichum must be used to perform a reliable and effective diagnosis.
Colletotrichum species DESCRIBED IN MEXICO
In Mexico, several Colletotrichum species have been reported as anthracnose causal agents in different hosts. Eighty two Colletotrichum species have been reported in monocotyledon plants such as corn (Zea mays) (Álvarez, 1976), henequen (Agave fourcroydes) (Quijano-Ramayo et al., 2002), sorghum (Sorghum vulgare) (Álvarez, 1976), as well as in dicotyledons such as banana (Musa spp.) (Marin et al., 1996), strawberry (Fragaria chiloensis var. Ananassa) (Fraire-Cordero et al., 2003) and rose (Rosa spp.) (Álvarez, 1976), among other crops.
Based on morphological characterization, 28 species have been described, 23 of which are anamorphic and 5 teleomorphic (Table 1). C. gloeosporioides is the most reported species according to the number of hosts. C. gloeosporioides morphological characteristics may vary even in the same host. A clear example of this are the results reported by Torres-Calzada et al. (2013), who identified six different morphotypes of C. gloeosporioides in papaya. The morphotypes presented cultural characteristics such as circular mycelial growth with entire or ondulate margin, white in color with orange conidial masses in the middle or distributed in concentric rings along the colony. Some of them developed olive-green, dark gray-to dark coloration with conidia 13.56 - 14.24 x 4 - 4.02 µm in average size.
Based on molecular characterization, 18 species have been reported: 15 species in anamorph stage and tree in teleomorph stage (Table 2). An integral identification was made (morphological and molecular) in most of the species; the latter was made based on analysis of the internal transcribed spacer (ITS). Although this genome region is not completely reliable, it is the most widely used because it includes a conserved organization in the genome of all eukaryotes (18S, 5.8S and 28S), it is found in repeated units and has a great number of copies, which facilitates its amplification and makes it useful to design primers. On the other hand, these conserved regions are separated by divergent, highly variable and polymorphic in length sequences that provide information and represent a genomic fingerprinting for each species (Rodríguez-Tovar et al., 2004).
Currently, identification at molecular level based on a single conserved region is not enough. Two or more regions are generally used. For example, for C. godetiae and C. karstii species the ITS and GADPH regions were used (Hernández-Lauzardo et al., 2015; Velázquez-del Valle et al., 2016), and for C. gigasporum, C. gloeosporioides, C. karstii, C. siamense and C. theobromicola species, the regions: ACT, CAL, GAPDH, TUB2 and ITS (Cristóbal-Martínez et al., 2017).
The reported species with a greater number of hosts are C. truncatum (6 hosts) and C. gloeosporioides (5 hosts), according to preliminary identification using the ITS region (primers ITS1-ITS4) and then using CcapF-CcapR and Cglnt-ITS4, respectively (Torres-Calzada et al., 2011b; Tapia-Tussell et al., 2008).
INFECTION PROCESS
In Colletotrichum species, progressive events take place during the pathogenicity process, including adherence to the host, germination (including formation of germ tubes), penetration (formation of melanized appressoria) and nutrition (colonization through intracellular hyphae and secondary infection hyphae). Today, we know the processes involved in differentiating the infectious structures of Colletotrichum spp., as well as the means of plant-pathogen interaction (Cannon et al., 2012).
The Colletotrichum species use two main infection strategies: hemibiotrophic intracellular and intramural subcuticular colonization. The preliminary infection stage is very similar in both: the conidium adheres, germinates on the surface of the plant, produces the germ tube, and then produces a melanized appresorium that directly penetrates the cuticle. However, the colonization process is different in both strategies (Perfect et al., 1999).
During the hemibiotrophic intracellular colonization, when penetrating the epidermic cells of the host, hyphae increases in size and form infection vesicles and a wide primary hypha around of which the plasmatic membrane invaginates. The infection vesicle and the primary hypha are surrounded by a interfacial matrix that keeps the host protoplast alive during that interaction stage. Then, the primary hypha progressively colonizes new epidermic and mesophile cells; primary hyphae produce thin necrotic secondary hyphae that quickly expand and degrade the cell walls through enzymes and cause necrotic lessions (Perfect et al., 1999).
Conversely, during the intramural subcuticular strategy, after penetrating, the pathogen develops under the cuticle and creates an intramural hyphae network. During the following infection stages, inter- and intracellular hyphae penetrate the epidermic and mesophile cells and cause the host to die (Perfect et al., 1999).
In Mexico, few studies about the infectious process of Colletotrichum in its interaction with its hosts have been conducted, and they have reported only that Colletotrichum species use a subcuticular intramural strategy and that the period during which the infection occurs varies depending on the host. Those studies, at a histological level, need to be complemented by gene expression studies focused on pathogenicity-related genes (Figure 3). Casarrubias-Carrillo et al. (2002) studied the infectious process of C. gloeosporioides in its interaction with papaya. Conidia germination and direct penetration took place between 48 and 72 h after inoculation (hai). Colonization through intercellular hyphae occurred between 90 and 120 hai. Eight days after inoculation, cells collapsed and separated, the cuticle broke and acervuli and conidia developed; as a result, the sunken lesions typical of anthracnose were formed. This indicated that in its interaction with papaya, C. gloeosporioides uses a subcuticular intramural strategy.
On the other hand, Villanueva-Arce et al. (2006) studied the pathogenesis of C. fragariae in its interaction with chirimoya. Conidia germinated on the epidermis and trichomes of unripe fruit, penetration was achieved directly through trichomes and epidermal cells through appressoria at 24 hai. The pathogen colonization was inter and intracelullar without visible biotrophic stage; after necrosis, subcuticular acervuli developed, and the life cyle of C. fragariae ended at 72 hai. This indicates that infection is produced through an intramural subcuticular strategy.
Rodríguez-López et al. (2013) studied the infection process of C. gloeosporioides in its interaction with avocado. The infection strategy used consisted of intramural subcuticular colonization. No direct penetration was observed throug appressoria. However, they observed a mucilaginous layer associated with the germ tubes; the colonization was intra- and intercellular, and the production of acervuli started 12 after inoculation.
Rojo-Báez et al. (2016) studied the infecction process of C. truncatum in its interaction with leaves of papaya and of pea. In both hosts, the penetration was directly achieved through appressoria at 20 hai (Figure 4A-B). In papaya, the colonization was inter- and intracellular (Figure 4C-D). In contrast, in pea, the colonization was intracellular; primary infection hyphae were observed at 36 hai, and secondary hyphae during the necrotrophic stage at 72 hai. Acervuli were observed in both hosts at 96 hai (Figure 4E). C. truncatum acted as an intramural subcuticular pathogen in papaya and as intracellular hemibiotroph in pea, which confirms that the infection strategy depends on the host.

Figure 4 Intramural subcuticularcolonization of C. truncatum in split papaya leaves cv. Maradol (Taken from Rojo-Báez et al., 2016). A) and B) penetration, A=appressorium, HI= hyphae from infection; C) y D) Colonization, Hi= intramural hyphae, HI= intracellular hyphae; E) Reproduction, acervuli with CO=conidiaand SE=setaeand F) healthy tissue, E=epidermis, MP=mesophylein palisade, ME=spongy mesophyll and D=druse.
Rojo-Báez et al. (2017) studied the infection process of C. truncatum in its interaction with papaya. Direct penetration through appressoria took place at 30 hai, intramural hyphae grew on the celullar walls of the epidermis between 30-48 hai, the necrotrophic colonization started at 72 hai, parenchyma cells were extensively degraded and the cuticle was broken through acervuli between 96-148 hai. Microscopic observation in papaya fruit showed that C. truncatum uses the subcuticular intramural infection strategy.
CONTROL
Controlling diseases caused by Colletotrichum/Glomerella mainly depends on cultural practices such as using disease-free seed, crop rotation, resistant crop varieties, remove dead branches and infected fruit; physical treatment (for example, hydrothermal treatment, ozone and modified atmospheres for fruit); chemical (fungicides) and biological control (extracts of plants, antagonistic microorganisms) (Phoulivong, 2011; Landero-Valenzuela et al., 2016).
As for chemical control, benzimidazole and strobilurin fungicides (that inhibit nuclear division and mitochondrial respiration, respectively) are widely used in the field. These fungicides are listed in the sanitary registry of plaguicides of the Comisión Federal para la Protección contra Riesgos Sanitarios (Torres-Calzada et al., 2015; COFEPRIS, 2017); azoxystrobin, clorotalonil, mancozeb and tiabendazole fungicides are also used for controling anthracnose in papaya and are registered by the Agencia de Protección al Ambiente (EPA) of the United States of America (Santamaría-Basulto et al., 2011).
In Mexico, there are pesticides whose use is banned or restricted due to their high risk to human health; there are also fungicides such as benzimidazoles, maneb and captafol, that are banned in other countries but whose use is authorized in Mexico. The reason that pesticides that have been taken off the market and banned in developed countries such as the US and Japan can be used in Mexico is possibly that Mexico’s pesticide regulations have not been updated and there is no constant monitoring to provide reliable results for establishing policies on pesticide use and management (Gutierrez-Alonso et al., 2004; Pérez et al., 2013).
On the other hand, it has been reported that because of the constant use of synthetic fungicides, Colletotrichum isolates have developed resistance. For example, Torres-Calzada et al. (2015) reported C. truncatum isolates resistant to azoxystrobin and tiabendazole, and susceptible to mancozeb and cyprodinil-fludioxonil fungicides. This confirms that the resistance to tiabendazol is caused by a mutation in the β-tubulin gen caused by the replacement of glutamic acid by alanine. The presence of resistant isolates to some chemical products has increased the interest in creating other control methods that are effective and safe for the end users and the environment, such as biological control.
There are examples of biological control of anthracnose in apple, papaya, avocado and mango, among other crops (Carrillo-Fasio et al., 2005; Landero-Valenzuela et al., 2016). Bacillus subtilis is widely used to control anthracnose due to its competitive and antibiotic antagonistic potential. Carrillo-Fasio et al. (2005) evaluated the efficacy of B. subtilis, Rhodotorula minuta and their combination in postharvest applications for controlling anthracnose (caused by C. gloeosporioides) in mango at postharvest level. The combination of R. minuta plus B. subtilis (106 + 104 ufc mL-1) was better than the chemical control (benomyl), which was promising for its commercial use. Futhermore, Patiño-Vera et al. (2005) developed a fermentation process at plant level-pilot to produce R. minuta yeast and then developed a low-cost formula to reduce anthracnose in mango.
Resistance inducers are also part of the methods for the control of Colletotrichum spp. Resistance induction to pathogens includes the use of physical, chemical and biological elicitors, including salicylic and jasmonic acids (Landero-Valenzuela et al., 2016). Other studies have been conducted focused on cultivar characterization of species resistant to Colletotrichum. Rodríguez-Guerra et al. (2006) suggested resistance genes in improved bean cultivars of commercial value in Mexico such as Negro INIFAP (that contains the resistance genes Co-1) and Negro 8025 (genes Co-6 or Co-8) resistant to most C. lindemuthianum pathotypes.
CONCLUSIONS
Colletotrichum species are important pathogens due to its wide range of hosts. In Mexico, this species has been identified mainly at the morphological level, but in recent studies a more extensive identification has been conducted based on morphological characterization and molecular analysis. Due to the existing complex of Colletotrichum species, in addition to the analysis of ITS regions, we need to include additional conserved regions. The major species reported in Mexico at morphological and molecular level are C. gloeosporioides and C. truncatum. Studies have been also conducted on pathogenesis and control for these species, but we still need to conduct further studies for other Colletotrichum spp. in order to establish future control strategies.
REFERENCES
Álvarez MG. 1976. Primer catálogo de enfermedades de plantas Mexicanas. Fitofilo 71:169 p. [ Links ]
Ávila-Quezada G, Silva-Rojas HV and Teliz-Ortiz D. 2007. First report of the anamorph of Glomerella acutata causing anthracnose on avocado fruits in Mexico. Plant Disease 91:1200. http://dx.doi.org/10.1094/PDIS-91-9-1200A [ Links ]
Barnett H y Hunter B. 1998. Ilustrated genera of imperfect fungi. Fourth Edition. APS Press. Minesota, USA. 197p. [ Links ]
Benítez-Camilo FA., Huerta-Palacios G, Holguín-Meléndez F y Toledo-Arreola J. 2003. Efecto de Colletotrichum gloeosporioides (Penz.) Penz. y Sacc. en la caída de frutos de mango cv. Ataulfo en el Soconusco, Chiapas, México. Revista Mexicana de Fitopatología 21:223-227. Disponible en línea: http://www.redalyc.org/articulo.oa?id=61221218 [ Links ]
Cai L, Hyde KD, Taylor PWJ, Weir BS, Waller JM, Abang MM, Zhang JZ, Yang YL, Phoulivong S, Liu ZY, Prihastuti H, Shivas RG, McKenzie EHC and Johnston PR. 2009. A polyphasic approach for studying Colletotrichum. Fungal Diversity 39:183-204. Disponible en línea: http://www.fungaldiversity.org/fdp/sfdp/FD39-8.pdf [ Links ]
Cannon PF, Damm U, Johnston PR and Weir BS. 2012. Colletotrichum - current status and future directions. Studies in Mycology 73:181-213. http://dx.doi.org/10.3114/sim0014 [ Links ]
Carrillo-Fasio JA, García-Estrada RS, Muy-Rangel MD, Sañudo-Barajas A, Márquez-Zequera I, Allende-Molar R, de la Garza-Ruiz Z, Patiño-Vera M y Galindo-Fentanes E. 2005. Control biológico de antracnosis [Colletotrichum gloeosporioides (Penz.) Penz. y Sacc.] y su efecto en la calidad postcosecha del mango (Mangifera indica L.) en Sinaloa, México. Revista Mexicana de Fitopatología 23:24-32. Disponible en línea: http://www.redalyc.org/articulo.oa?id=61223104 [ Links ]
Casarrubias-Carrillo U, Cárdenas-Soriano E, Nieto-Ángel D y Gutierrez-Alonso JG. 2002. Histopatología de frutos de papaya (Carica papaya L.) infectados por Colletotrichum gloeosporioides Penz. Revista Mexicana de Fitopatología 20:88-93. Disponible en línea: http://www.socmexfito.org/2014-01-08-17-34-56/2013-06-19-02-09-15/001-vol-20/101-revista-smf/2002/001/234-histopatologia-de-frutos-de-papaya-carica-papaya-l-infectados-por-colletotrichum-gloeosporioides-penz [ Links ]
Casarrubias-Carrillo U, González-Chavira MM, Cruz-Hernández A, Cárdenas-Soriano E, Nieto-Ángel D y Guevara-González RG. 2003. Variabilidad genética de Colletotrichum gloeosporioides (Penz.) Penz. y Sacc. aislado de frutos de papaya (Carica papaya L.) mediante el uso de marcadores moleculares RAPD. Revista Mexicana de Fitopatología 21:338-345. Disponible en línea: http://www.redalyc.org/articulo.oa?id=61221315 [ Links ]
COFEPRIS, Comisión Federal para la Protección contra Riesgos Sanitarios. 2017. Registro sanitario de plaguicidas y nutrientes vegetales. http://www.cofepris.gob.mx (Consulta, Febrero 2017). [ Links ]
Cristóbal-Martínez AL, Yáñez-Morales MJ, Solano-Vidal R, Segura-León O and Hernández-Anguiano AM. 2017. Diversity of Colletotrichum species in coffee (Coffea arabica) plantations in Mexico. European Journal of Plant Pathology 147:605-614. http://dx.doi.org/10.1007/s10658-016-1029-0 [ Links ]
Crouch JA, Clarke BB, White JJF and Hillman BI. 2009a. Systematic analysis of the falcate spored graminicolous Colletotrichum and a description of six new species from warm-season grasses. Mycologia 101:717-732. http://dx.doi.org/10.3852/08-230 [ Links ]
Crouch JA, Clarke BB and Hillman BI. 2009b. What is the value of ITS sequence data in Colletotrichum systematics and species diagnosis? A case study using the falcate-spored graminicolous Colletotrichum group. Mycologia 101:648-656. http://dx.doi.org/10.3852/08-231 [ Links ]
Crouch JA, O’Connell R, Gan P, Buiate E, Torres MF, Beirn L, Shirasu K and Vaillancourt L. 2014. The genomics of Colletotrichum. Pp. 69-102. In: Dean RA, Lichens-Park A y Kole C (eds.) Genomics of Plant-Associated Fungi: Monocot Pathogens. Vol 1. Springer-Verlag, Berlin, Heidelberg, Alemania. 201p. http://dx.doi.org/10.1007/978-3-662-44053-7 [ Links ]
Damm U, Woudenberg JHC, Cannon PF and Crous PW. 2009. Colletotrichum species with curved conidia from herbaceous host. Fungal Diversity 39:45-87. Disponible en línea: http://www.fungaldiversity.org/fdp/jinds3.php#vol39 [ Links ]
Damm U, Baroncelli R, Cai L, Kubo Y, O´Connell R, Weir B, Yoshino K and Cannon PF. 2010. Colletotrichum: species, ecology and interactions. International Mycological Association Fungus 1:161-165. Disponible en línea: https://www.ncbi.nlm.nih.gov/pmc/articles/PMC3348780/ [ Links ]
Damm U, Cannon PF, Woudenberg JHC and Crous PW. 2012a. The Colletotrichum acutatum species complex. Studies in Mycology 73:37-113. http://dx.doi.org/10.3114/sim0010 [ Links ]
Damm U, Cannon PF, Woudenberg JHC, Johnston PR, Weir BS, Tan YP, Shivas RG and Crous PW. 2012b. The Colletotrichum boninense species complex. Studies in Mycology 73:1-36. http://dx.doi.org/10.3114/sim0002 [ Links ]
Damm U, Cannon PF, Liu F, Barreto RW, Guantimosim E and Crous PW. 2013. The Colletotrichum orbiculare especies complex: Important pathogens of field crops and weeds. Fungal Diversity 61:29-59. http://dx.doi.org/10.1007/s13225-013-0255-4 [ Links ]
Damm U, O’ Connell RJ, Groenewald JZ and Crous PW. 2014. The Colletotrichum destructivum species complex - hemibiotrophic pathogens of forage and field crops. Studies in Mycology 79:49-84. http://dx.doi.org/10.1016/j.simyco.2014.09.003 [ Links ]
Dean R, Van JAL, Preorius ZA, Hammond-Kosack KE, Di PA, Spanu PD, Rudd JJ, Dickman M, Kahmann R, Ellis J and Foster GD. 2012. The top 10 fungal pathogens in molecular plant pathology. Molecular Plant Pathology 13:414-430. http://dx.doi.org/10.1111/J.1364-3703.2011.00783.x [ Links ]
Farr DF, Aime MC, Rossman AY and Palm ME. 2006. Species of Colletotrichum on Agavaceae. Mycological Research 110:1395-1480. http://dx.doi.org/10.1016/j.mycres.2006.09.001 [ Links ]
Fernández-Pavía SP, Rodríguez-Alvarado G, Gómez-Dorantes N, Gregorio-Cipriano MR y Fernández-Pavía L. 2012. Enfermedades en plantas en el estado de Michoacán. Biológicas 14:75-89. Disponible en línea: http://www.biologicas.umich.mx/index.php/biologicas/article/view/140 [ Links ]
Fernández-Pavía SP, Gregorio-Cipriano R, Rodríguez-Alvarado G, Fernández-Pavía L, Mondragón FA, Gómez-Dorantes N, Lozoya-Saldaña H, Rodríguez-Fernández R y Herrera CJ. 2015. Enfermedades de especies vegetales en México. Primera edición. Morevalladolid. Morelia, Michoacán, México. 425p. [ Links ]
Fraire-Cordero ML, Yáñez Morales MJ, Nieto-Ángel D, y Vázquez-Gálvez G. 2003. Hongos patógenos en fruto de fresa (Fragaria x ananassa Duch.) en postcosecha. Revista Mexicana de Fitopatología 21:285-291. Disponible en línea: http://www.redalyc.org/articulo.oa?id=61221307 [ Links ]
Fucikovsky L and Luna I. 1987. Avocado fruit diseases and their control in Mexico. South African Avocado Growers’Association Yearbook 10:119-121. Disponible en línea: http://www.avocadosource.com [ Links ]
Groenewold-Labrada B, Mayek-Pérez N y Padilla-Ramírez JS. 2003. Hongos asociados a la semilla de frijol (Phaseolus vulgaris L.) en Aguascalientes, México. Revista Mexicana de Fitopatología 21:375-378. Disponible en línea: http://www.redalyc.org/articulo.oa?id=61221320 [ Links ]
Gutiérrez-Alonso O, Nieto-Ángel D, Gutiérrez-Alonso JG, Delgadillo-Sánchez F. y Domínguez-Álvarez JL. 2002. Características morfológicas, culturales y patogenicidad de aislamientos de Colletotrichum spp. obtenidos de frutos de guayaba (Psidium guajava L.). Revista Mexicana de Fitopatología 20:24-30. Disponible en línea: http://www.redalyc.org/articulo.oa?id=61220105 [ Links ]
Gutiérrez-Alonso JG, Gutiérrez-Alonso O,Nieto-Ángel D, Téliz-Ortiz D, Zavaleta-Mejía E y Delgadillo-Sánchez F. 2004. Manejo integrado de la antracnosis [Colletotrichum gloeosporioides (Penz.) Penz. y Sacc.] del mango (Mangifera indica L.) durante la postcosecha. Revista Mexicana de Fitopatología 22:395-402. Disponible en línea: http://www.redalyc.org/articulo.oa?id=61222313 [ Links ]
Hernández-Lauzardo AN, Campos-Martínez A, Velázquez-del Valle MG y Flores-Moctezuma HE. 2015. First report of Colletotrichum godetiae causing anthracnose on avocado in Mexico. Plant Disease 99:555. http://dx.doi.org/10.1094/PDIS-10-14-1019-PDN [ Links ]
Hyde KD, Cai L, Cannon PF, Crouch JA, Crous PW, Damm U et al. 2009a. Colletotrichum - names in current use. Fungal Diversity 39:147-182. Disponible en línea: http://www.fungaldiversity.org/fdp/sfdp/FD39-7.pdf [ Links ]
Hyde KD, Cai L, McKenzie EHC, Yang YL, Zhang JZ and Prihastuti H. 2009b. Colletotrichum: a catalogue of confusión. Fungal Diversity 39:1-17. Disponible en línea: http://www.fungaldiversity.org/fdp/sfdp/FD39-1-E.pdf [ Links ]
Hyde KD, Nilsson RH, Alias SA, Ariyawansa HA, Blair JE, et al. 2014. One stop shop: backbones trees for important phytopathogenic genera: I (2014). Fungal Diversity 67:21-125. http://dx.doi.org/10.1007/s13225-014-0298-1 [ Links ]
Lagunes-Castro MS, López-Monteon A, Ramos-Ligonio A, Trigos A, Salinas A y Espinoza C. 2015. Actividad antibacteriana de extractos metanol:cloroformo de hongos fitopatógenos. Revista Mexicana de Fitopatología 33: 87-94. Disponible en línea: http://www.redalyc.org/articulo.oa?id=61240687008 [ Links ]
Landero-Valenzuela N, Lara-Viveros FM, Andrade-Hoyos P, Aguilar-Pérez LA y Aguado RGJ. 2016. Alternativas para el control de Colletotrichum spp. Revista Mexicana de Ciencias Agrícolas 7:1189-1198. Disponible en línea: http://www.redalyc.org/articulo.oa?id=263146723018 [ Links ]
Leyva-Mir SG, Soto-Herrera A, Espitia-Rangel E, Villaseñor-Mir HE, González-Iñiguez RM y Huerta-Espino J. 2004. Etiología e incidencia de la antracnosis [Colletotrichum graminicola (Ces.) G.W. Wils.] de la avena (Avena sativa L.) en Michoacán, México. Revista Mexicana de Fitopatología 22:351-355. Disponible en línea: http://www.redalyc.org/articulo.oa?id=61222306 [ Links ]
Lira-Saldivar RH, Hernández-Suárez M and Hernández-Castillo FD. 2006. Activity of Larrea tridentata (D.C.) Coville L. extracts and chitosan against fungi that affect horticultural crops. Revista Chapingo Serie Horticultura 12:211-216. Disponible en línea: http://www.redalyc.org/articulo.oa?id=60912212 [ Links ]
Macedo CA, Martínez HA y Lara RJ. 2012. Rizobacterias aisladas del trópico húmedo con actividad antagónica sobre Colletotrichum gloeosporioides, evaluación cuantitativa e identificación molecular. Revista Mexicana de Fitopatología 30:11-30. Disponible en línea: http://www.redalyc.org/articulo.oa?id=61225129002 [ Links ]
Marin DH, Sutton TB, Blankenship SM and Swallow WH. 1996. Pathogenicity of fungi associated with Crown rot of bananas in Latin America on Grande Naine and disease-resistant hybrid bananas. Plant Disease 80:525-528. Disponible en línea: http://www.apsnet.org/publications/PlantDisease/BackIssues/Documents/1996Abstracts/PD_80_525.htm [ Links ]
Martínez-Bolaños M, Téliz-Ortiz D, Mora-Aguilera A, Valdovinos-Ponce G, Nieto-Ángel D, García-Pérez E y Sánchez-López V. 2015. Anthracnose (Colletotrichum gloeosporioides Penz.) of Litchi Fruit (Litchi chinensis Soon.) in Oaxaca, Mexico. Revista Mexicana de Fitopatología 33:140-155. Disponible en línea: http://www.redalyc.org/articulo.oa?id=61242145002 [ Links ]
Montes-Belmont R, Nava-Juárez RA, Flores-Moctezuma HE y Mundo-Ocampo M. 2003. Hongos y nematodos en raíces y bulbos de cebolla (Allium cepa L.) en el estado de Morelos, México. Revista Mexicana de Fitopatología 21:300-304. Disponible en línea: http://www.redalyc.org/articulo.oa?id=61221309 [ Links ]
Nava-Díaz C, Osada-Kawasoe S, Rendón-Sánchez G y Ayala-Escobar V. 2000. Organismos asociados a Chirimoyo (Annona cherimola Mill.) en Michoacán, México. Agrociencia 34:217-226. Disponible en linea: http://www.redalyc.org/articulo.oa?id=30234211 [ Links ]
Orozco-Santos M, Manzo-Sánchez G, Guzmán-González S, Farías-Larios J y Timmer LW. 2004. Crecimiento y cambios morfológicos de Colletotrichum acutatum Simmonds, agente causal de la antracnosis del limón Mexicano (Citrus aurantifolia Christm. Swingle) incubado en diferentes medios de cultivo sólidos y líquidos. Revista Mexicana de Fitopatología 22:423-428. Disponible en línea: http://www.redalyc.org/articulo.oa?id=61222316 [ Links ]
Ortega-Acosta SA, Hernández-Morales J, Sandoval- Islas JS, Ayala-Escobar V, Soto-Rojas L y Alejo-Jaimes A. 2015. Distribución y Frecuencia de Organismos Asociados a la Enfermedad “Pata Prieta” de la Jamaica (Hibiscus sabdariffa L.), en Guerrero, México. Revista Mexicana de Fitopatología 33: 173-194. Disponible en línea: http://www.redalyc.org/articulo.oa?id=61242145004 [ Links ]
Patiño-Vera M, Jiménez B, Balderas K, Ortiz M, Allende R, Carrillo A and Galindo E. 2005. Pilot-scale production and liquid formulation of Rhodotorula minuta, a potential biocontrol agent of mango anthracnose. Journal of Applied Microbiology 99:540-550. http://dx.doi.org/10.1111/j.1365-2672.2005.02646.x [ Links ]
Pérez MA, Navarro H y Miranda E. 2013. Residuos de plaguicidas en hortalizas: problemática y riesgo en México. Revista Internacional de Contaminación Ambiental 29:45-64. Disponible en línea: http://www.redalyc.org/articulo.oa?id=37028958003 [ Links ]
Perfect ES, Hughes BH, O´Connell JR and Green RJ. 1999. Colletotrichum: a model genus for studies on pathology and fungal-plant interactions. Fungal Genetics and Biology 27:186-198. http://dx.doi.org/10.1006/fgbi.1999.1143 [ Links ]
Phoulivong S. 2011. Colletotrichum, naming, control, resistance, biocontrol of weeds and current challenges. Current Research in Environmental & Applied Mycology 1:53-75. Disponible en línea: http://www.creamjournal.org/volume-1/issue-1.html [ Links ]
Quijano-Ramayo A, Herrera-Herrera JL, Canul-Salazar M. y Robert ML. 2002. Microbial diseases affecting henequen (Agave fourcroydes Lem.) in Yucatan, Mexico. Revista Mexicana de Fitopatología 20:18-23. Disponible en línea: http://www.redalyc.org/articulo.oa?id=61220104 [ Links ]
Réblová M, Gams W and Seifert KA. 2011. Monilochaetes and allied genera of the Glomerellales, and a reconsideration of families in the Microascales. Studies in Mycology 68:163-191. http://dx.doi.org/10.3114/sim.2011.68.07 [ Links ]
Rodríguez-Guerra R, Ramírez-Rueda MT, Martínez VO and Simpson J. 2003. Variation in genotype, pathotype and anastomosis groups of Colletotrichum lindemuthianum isolates from Mexico. Plant Pathology 52:228-235. http://dx.doi.org/10.1046/j.1365-3059.2003.00808.x [ Links ]
Rodríguez-Guerra R, Ramírez-Rueda MT, Cabral-Enciso M, García-serrano M, Lira-Maldonado Z and Guevara-González G. 2005. Heterothallic mating observed between Mexican isolates of Glomerella lindemuthiana. Mycologia 97:793-803. http://dx.doi.org/10.3852/mycologia.97.4.793 [ Links ]
Rodríguez-Guerra R, Acosta-Gallegos JA, González-Chavira MM y Simpson J. 2006. Patotipos de Colletotrichum lindemuthianum y su implicación en la generación de cultivares resistentes de frijol. Agricultura Técnica en México 32:101-114. Disponible en línea: http://www.scielo.org.mx/scielo.php?script=sci_arttext&pid=S0568-25172006000100010 [ Links ]
Rodríguez-López ES, Cárdenas-Soriano E, Hernández-Delgado S, Gutiérrez-Diez A y Mayek-Pérez N. 2013. Análisis de la infección de Colletotrichum gloeosporioides (Penz.) Penz. & Sacc. de frutos de aguacatero. Revista Brasileira de Fruticultura 35:898-905. http://dx.doi.org/10.1590/S0100-29452013000300029 [ Links ]
Rodríguez-Tovar A, Xoconostle-Cásarez B y Valdés M. 2004. Ecología molecular de los hongos ectomicorrízicos. Revista Fitotecnia Mexicana 27:267-278. Disponible en línea: http://www.redalyc.org/articulo.oa?id=61027307 [ Links ]
Rojo-Báez I, García-Estrada RS, León-Félix J, Sañudo-Barajas A y Allende-Molar R. 2016. Histopatología del proceso de infección de Colletotrichum truncatum en hojas de papaya y chícharo. Revista Mexicana de Fitopatología 34: 316-325. http://dx.doi.org/10.18781/R.MEX.FIT.1604-3 [ Links ]
Rojo-Báez I, García-Estrada RS, Sañudo-Barajas A, León-Félix J y Allende-Molar R. 2017. Proceso de infección de antracnosis por Colletotrichum truncatum en papaya Maradol. Revista Brasileira de Fruticultura 39: 1-5. http://dx.doi.org/10.1590/0100-29452017379 [ Links ]
Sánchez-García BM, Flores-olivas A, Sánchez-Arizpe A, Pineda-Rodríguez S, López-Jiménez G, Fraire-Velásquez S, Garrido-Ramírez ER, Acosta-Gallegos JA, Simpson WJ y Rodríguez-Guerra R. 2009. Patotipos de Colletotrichum lindemuthianum en Oaxaca y San Luis Potosí, México y resistencia en genotipos de frijol. Agricultura Técnica en México 35:49-60. Disponible en línea: http://www.redalyc.org/articulo.oa?id=60835105 [ Links ]
Santamaría-Basulto F, Díaz-Plaza R, Gutiérrez-Alonso O, Santamaría-Fernández J y Larqué-Saavedra A. 2011. Control de dos especies de Colletotrichum y su efecto sobre el color y sólidos solubles totales en frutos de papaya Maradol. Revista Iberoamericana de Tecnología Postcosecha 12:19-27. Disponible en línea: http://www.redalyc.org/articulo.oa?id=81318808004 [ Links ]
Schoch CL, Seifert KA, Huhndorf S, Robert V, Spouge JL, Levesque CA, Chen W and Fungal Barcoding Consortium. 2012. Nuclear ribosomal internal transcribed spacer (ITS) region as a universal DNA barcode marker for Fungi. Proceedings of the National Academy of Sciences 109:6241-6246. http://dx.doi.org/10.1073/pnas.1117018109 [ Links ]
Silva-Rojas HV and Ávila-Quezada GD. 2011. Phylogenetic and morphological identification of Colletotrichum boninense: a novel causal agent of anthracnose in avocado. Plant Pathology 60:899-908. http://dx.doi.org/10.1111/j.1365-3059.2011.02452.x [ Links ]
Tapia-Tussell R, Quijano-Ramayo A, Cortes-Velázquez A, Lappe P, Larque-Saavedra A and Perez-Brito D. 2008. PCR-based detection and characterization of the fungal pathogens Colletotrichum gloeosporioides and Colletotrichum capsici causing anthracnose in papaya (Carica papaya L.) in the Yucatan península. Molecular Biotechnology 40:293-298. http://dx.doi.org/10.1007/s12033-008-9093-0 [ Links ]
Tapia-Tussell R, Cortes-Velázquez A, Valencia-Yah, Navarro C, Espinosa E, Moreno B and Perez-Brito D. 2016. First report of Colletotrichum magnum causing anthracnose in papaya in Mexico. Plant Disease 100:2323. http://dx.doi.org/10.1094/PDIS-03-16-0324-PDN [ Links ]
Torres-Calzada C, Tapia-Tussell R, Garcez-Nexticapan A, Matin-Mex R, Quijano-Ramayo A, Cortes-Velázquez A, Higuera-Ciapara I and Perez-Brito D. 2011a. First report of Colletotrichum capsici causing anthracnose in Jatropha curcas in Yucatan, Mexico. New Disease Reports 23:6. http://dx.doi.org/10.5197/j.2044-0588.2011.023.006 [ Links ]
Torres-Calzada C, Tapia-Tussell R, Quijano-Ramayo A, Matin-Mex R, Rojas-Herrera R, Higuera-Ciapara I and Pérez-Brito D. 2011b. A species-specific polymerase chain reaction assay for rapid and sensitive detection of Colletotrichum capsici. Molecular Biotechnology 49:48-55. http://dx.doi.org/10.1007/s12033-011-9377-7 [ Links ]
Torres-Calzada C, Tapia-Tussell R, Higuera-Ciapara I and Perez-Brito D. 2013. Morphological, pathological and genetic diversity of Colletotrichum species responsable for anthracnose in papaya (Carica papaya L). European Plant Pathology 135:67-79. http://dx.doi.org/10.1007/s10658-012-0065-7 [ Links ]
Torres-Calzada C, Tapia-Tussell R, Higuera-Ciapara I, Martin-Mex R, Nexticapan-Garcez A, and Perez-Brito D. 2015. Sensitivity of Colletotrichum truncatum to four fungicides and characterization of thiabendazole-resistant isolates. Plant Disease 99:1590-1595. http://dx.doi.org/10.1094/PDIS-11-14-1183-RE [ Links ]
Udayanga D, Manamgoda DS, Liu X, Chukeatirote E and Hyde KD. 2013. What are the common anthracnose pathogens of tropical fruits? Fungal Diversity 61:165-179. http://dx.doi.org/10.1007/s13225-013-0257-2 [ Links ]
Velázquez-del Valle MG, Campos-Martínez A and Flores-Moctezuma HE. 2016. First report of avocado anthracnose caused by Colletotrichum karstii in Mexico. Plant Disease 100:534. http://dx.doi.org/10.1094/PDIS-03-15-0249-PDN [ Links ]
Villanueva-Arce R, Hernández-Anguiano AM, Yáñez-Morales MJ, Téliz-Ortíz D, Mora-Aguilera A, Cárdenas-Soriano E y Castañeda-Vildózola A. 2005. Caracterización e identificación de Colletotrichum fragariae en frutos de chirimoya. Agrociencia 39:93-106. Disponible en línea: http://www.redalyc.org/articulo.oa?id=30239109 [ Links ]
Villanueva-Arce R, Cárdenas-Soriano E, Hernández-Anguiano AM, Mora-Aguilera A y Téliz-Ortíz D. 2006. Patogénesis de la antracnosis (Colletotrichum fragariae) en frutos de chirimoya. Agrociencia 40:773-782. Disponible en línea: http://www.redalyc.org/articulo.oa?id=30240609 [ Links ]
Villanueva-Arce R, Yáñez-Morales MJ, Téliz-Ortíz D y Hernández-Anguiano AM, 2008. Especies de Colletotrichum en chirimoya (Annona cherimola Mill). Agrociencia 42:689-701. Disponible en línea: http://www.redalyc.org/articulo.oa?id=30211218009 [ Links ]
Weir BS, Johnston PR and Damm U. 2012. The Colletotrichum gloeosporioides species complex. Studies in Mycology 73:115-180. http://dx.doi.org/10.3114/sim0011 [ Links ]
Zhang N, Castlebury LA, Miller AN, Huhndorf SM, Schoch CL, Seifert KA, Rossman AY, Rogers JD, Volkmann-Kohlmeyer JKB and Sung GH. 2006. An overview of the systematics of the Sordariomycetes based on a four-gene phylogeny. Mycologia 98:1076-1087. http://dx.doi.org/10.3852/mycologia.98.6.1076 [ Links ]
Zhang N, Rossman AY, Seifert K, Bennett JW, Cai G, Cai L, Hillman B, Hyde KD, Luo J, Manamgoda D, Meyer W, Molnar T, Schoch C, Tadych M and White JF Jr. 2013. Impacts of the International Code of Nomenclature for algae, fungi and plants (Melbourne Code) on the scientific names of plant pathogenic fungi. APS Feature. http://dx.doi.org/10.1094/APSFeature-2013-06. [ Links ]
Zavala-león MJ, Tun-Suárez JM, Cristóbal-Alejo J, Ruiz-Sánchez E, Gutiérrez-Alonso O, Vázquez-Calderón M y Méndez-González R. 2005. Control postcosecha de la antracnosis en papaya y sensibilidad de Colletotrichum gloeosporioides (Penz.) Sacc. a fungicidas organosintéticos. Revista Chapingo Serie Horticultura 11:251-255. Disponible en línea: http://www.redalyc.org/articulo.oa?id=60911210 [ Links ]
Acknowledgments
Received: March 29, 2017; Accepted: May 09, 2017











 texto en
texto en 





